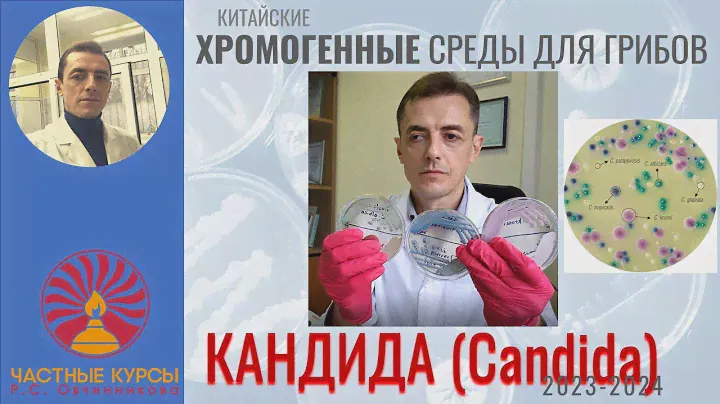

106 ₽
106 ₽
106 ₽






















Алюминий первичный А7, А99, А85, А8, А5, ГОСТ 11069-2019 цена
PT6M58Strue0001-01-01 00:00:00 +0000 UTC

Производство вторичного алюминия. MADE.BY
PT6M58Strue0001-01-01 00:00:00 +0000 UTC

Торговля между странами БРИКС: проблемы и перспективы #николайплатошкин #актуально #россия #брикс
PT6M58Strue0001-01-01 00:00:00 +0000 UTC

Обзор хромогенной среды для грибов Кандида (Candida) производства Китай (2023-2024)
PT6M58Strue0001-01-01 00:00:00 +0000 UTC
Nissan разработал быстрый и дешёвый метод производства углепластика
PT6M58Strue0001-01-01 00:00:00 +0000 UTC

Штамповка днища реактора для третьего блока АЭС «Аккую» на Волгодонском Атоммаше
PT6M58Strue0001-01-01 00:00:00 +0000 UTC
